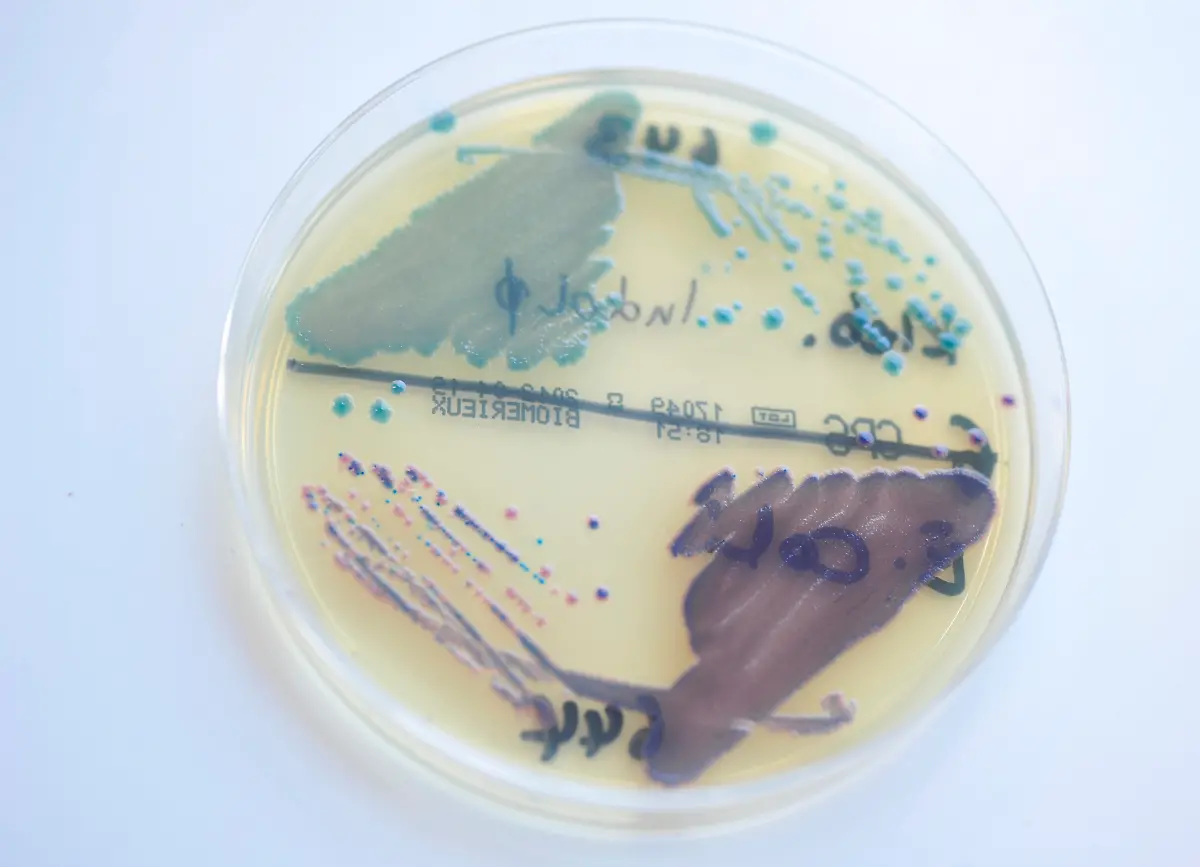
30066075
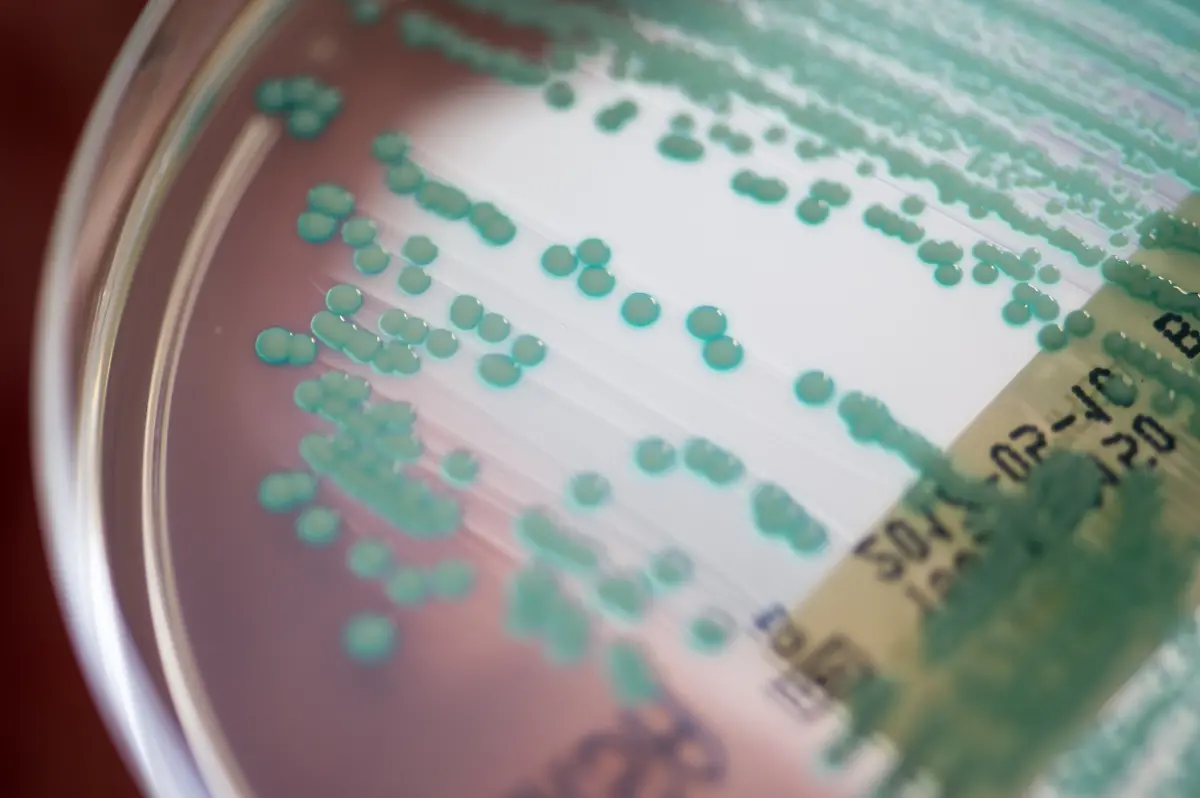
384975245

Bilderserien

WHO-Liste des GrauensDie gefährlichsten Erreger, gegen die es keine Impfung gibt
29.12.2024, 08:55 Uhr
Ob HIV, Malaria oder multiresistente Keime: Gegen viele Erreger gibt es noch keinen wirksamen Impfstoff. Sie verursachen daher immer wieder Infektionen und Ausbrüche, gegen die nur wenig unternommen werden kann. Die WHO listet nun die 17 gefährlichsten dieser Viren und Bakterien auf.